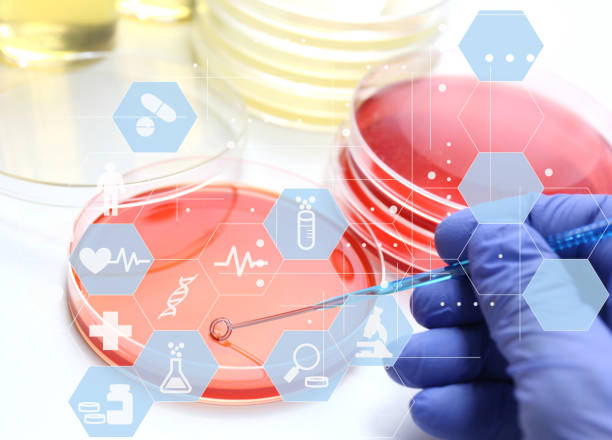
آموزش سئو برای آزمایشگاههای تخصصی پاتوبیولوژی در مشهد: بهینهسازی نوبتدهی آنلاین و یکپارچهسازی CRM پزشکی 2026 - سئو آزمایشگاه پاتوبیولوژی و افزایش مراجعین آزمایشگاه

در دنیای پرشتاب امروز، حضور دیجیتال برای هر کسبوکاری، به ویژه در حوزه حساس و تخصصی پزشکی، از یک مزیت رقابتی به یک ضرورت حیاتی تبدیل شده است. آزمایشگاههای پاتوبیولوژی نیز از این قاعده مستثنی نیستند. در شهری مانند مشهد، که قطب مهمی در گردشگری سلامت و خدمات درمانی به شمار میرود، رقابت میان مراکز تشخیصی فشردهتر از همیشه است. مراجعین امروز، پیش از هر اقدامی، به دنبال اطلاعات آنلاین هستند؛ از یافتن نزدیکترین آزمایشگاه تا مشاهده خدمات، نوبتدهی آنلاین و حتی بررسی اعتبار و نظرات سایر بیماران. اینجاست که نقش سئو آزمایشگاه پاتوبیولوژی بیش از پیش پررنگ میشود.
این مقاله، راهنمایی جامع و کاربردی برای مدیران و متخصصان آزمایشگاههای پاتوبیولوژی در مشهد است تا با استفاده از راهکارهای پیشرفته سئو، نه تنها در صدر نتایج موتورهای جستجو قرار گیرند، بلکه تجربه کاربری مراجعین خود را بهبود بخشیده و با یکپارچهسازی CRM پزشکی، روابط پایداری با آنها برقرار سازند. ما قدم به قدم به بررسی استراتژیهایی میپردازیم که منجر به افزایش مراجعین آزمایشگاه، بهینهسازی فرآیند نوبتدهی آنلاین و در نهایت، تقویت جایگاه برند شما در فضای دیجیتال ۲۰۲۶ خواهد شد.
نیاز به یک وبسایت تخصصی و سئو قوی برای آزمایشگاه خود دارید؟
تیم متخصص پینو سایت با استفاده از جدیدترین تکنولوژیها مانند لاراول، ریاکت، ویو و نود جیاس، آماده است تا وبسایتی حرفهای و کاملاً بهینهسازی شده برای آزمایشگاه شما طراحی و پیادهسازی کند. ما نه تنها به طراحی وبسایت شما اهمیت میدهیم، بلکه با استراتژیهای سئو تخصصی پزشکی، افزایش مراجعین آزمایشگاه را تضمین میکنیم.
تلفن: ۰۹۹۲۷۰۲۸۴۶۳
آموزش سئو برای آزمایشگاههای تخصصی پاتوبیولوژی در مشهد: بهینهسازی نوبتدهی آنلاین و یکپارچهسازی CRM پزشکی ۲۰۲۶
فهرست مطالب
- اهمیت حضور دیجیتال برای آزمایشگاههای پاتوبیولوژی در مشهد
- اصول اولیه سئو و نحوه عملکرد آن برای آزمایشگاهها
- تحقیق کلمات کلیدی تخصصی برای آزمایشگاههای پاتوبیولوژی
- بهینهسازی سیستم نوبتدهی آنلاین آزمایشگاه: کلید جذب مراجعین بیشتر
- نقش CRM پزشکی در مدیریت ارتباط با بیمار و سئو
- استراتژیهای سئو محلی (Local SEO) برای آزمایشگاههای مشهد
- تولید محتوای ارزشمند و تخصصی برای آزمایشگاه
- بکلینکسازی و افزایش اعتبار دامنه (Domain Authority)
- بازاریابی دیجیتال فراتر از سئو برای آزمایشگاهها
- نکات حرفهای برای نگهداری و بهبود مستمر سئو
- سوالات متداول (FAQ)
- نتیجهگیری و گامهای بعدی
اهمیت حضور دیجیتال برای آزمایشگاههای پاتوبیولوژی در مشهد
در سال ۲۰۲۶، با پیشرفت روزافزون فناوری و دسترسی بیسابقه به اینترنت، بیماران و مراجعین انتظار دارند که بتوانند خدمات درمانی مورد نیاز خود را به راحتی و سرعت در فضای آنلاین پیدا کنند. برای آزمایشگاههای پاتوبیولوژی، این به معنای فراتر رفتن از تابلوهای سنتی و ورود قاطع به دنیای دیجیتال است. حضور قوی آنلاین نه تنها افزایش مراجعین آزمایشگاه را در پی دارد، بلکه باعث ساخت برند، افزایش اعتبار و سهولت دسترسی به خدمات برای بیماران میشود.
مخصوصاً در شهری مانند مشهد که جمعیت زیادی دارد و تعداد مراکز درمانی و آزمایشگاهها نیز بالاست، دیده شدن در میان رقبا یک چالش اساسی است. یک وبسایت حرفهای با سئو آزمایشگاه پاتوبیولوژی قوی، به بیماران کمک میکند تا شما را در لحظه نیاز پیدا کنند. این حضور آنلاین شامل موارد زیر میشود:
- دسترسی آسان به اطلاعات: ساعات کاری، لیست خدمات، آدرس دقیق، راههای ارتباطی.
- امکان نوبتدهی آنلاین: سهولت فرآیند برای بیماران و کاهش بار کاری پذیرش.
- دسترسی به نتایج آزمایش: ارائه امن و سریع نتایج به صورت آنلاین.
- محتوای آموزشی: فراهم کردن اطلاعات مورد نیاز بیماران در مورد آزمایشها و آمادگیهای لازم.
اصول اولیه سئو و نحوه عملکرد آن برای آزمایشگاهها
سئو یا بهینهسازی موتور جستجو (Search Engine Optimization) مجموعهای از تکنیکها و استراتژیهاست که هدف آن بهبود رتبه وبسایت شما در نتایج موتورهای جستجو مانند گوگل است. برای آزمایشگاه پاتوبیولوژی، سئو به معنای اطمینان از این است که وقتی کسی عبارتهایی مانند “آزمایشگاه پاتوبیولوژی مشهد”، “آزمایش دیابت مشهد” یا “نوبتدهی آنلاین آزمایش” را جستجو میکند، وبسایت شما در میان اولین نتایج نمایش داده شود.
سئو سه ستون اصلی دارد که در ادامه به تفصیل توضیح داده میشوند:
سئو داخلی (On-Page SEO)
این بخش شامل تمامی اقداماتی است که میتوانید مستقیماً در وبسایت خود انجام دهید تا آن را برای موتورهای جستجو و کاربران بهینه کنید. طراحی وبسایت شما نقش حیاتی در این بخش دارد.
- کلمات کلیدی: استفاده از کلمات کلیدی مرتبط در عنوان، توضیحات متا، هدینگها (H1, H2, H3) و متن اصلی.
- محتوای با کیفیت: ارائه محتوای جامع، دقیق و مفید که به سوالات کاربران پاسخ دهد و ارزش ارائه کند. این محتوا میتواند شامل توضیحات آزمایشها، مقالات پزشکی و راهنماهای آمادگی باشد.
- ساختار URL: داشتن URLهای کوتاه، خوانا و حاوی کلمات کلیدی.
- بهینهسازی تصاویر: استفاده از تگ Alt مناسب برای تصاویر حاوی کلمات کلیدی.
- سرعت بارگذاری صفحه: سرعت وبسایت عامل مهمی در تجربه کاربری و رتبهبندی گوگل است. پینو سایت در طراحی وبسایت همواره به این نکته توجه ویژه دارد.
- ریسپانسیو بودن (Mobile-Friendliness): اطمینان از اینکه وبسایت شما در تمامی دستگاهها (موبایل، تبلت، دسکتاپ) به خوبی نمایش داده میشود.
سئو خارجی (Off-Page SEO)
این بخش به فعالیتهایی اشاره دارد که خارج از وبسایت شما انجام میشود اما بر رتبه شما تأثیر میگذارد. هدف اصلی، افزایش اعتبار (Authority) و اعتماد (Trust) وبسایت است.
- بکلینکسازی (Backlinking): دریافت لینک از وبسایتهای معتبر و مرتبط (مثل وبسایتهای پزشکی، دانشگاهی، خبری).
- حضور در شبکههای اجتماعی: فعالیت و تعامل در پلتفرمهایی مانند اینستاگرام و لینکدین برای افزایش آگاهی از برند و ترافیک ارجاعی.
- برندینگ و شهرت آنلاین: مدیریت نظرات و بررسیها در پلتفرمهای مختلف.
سئو تکنیکال (Technical SEO)
این جنبه از سئو به بهبود زیرساخت فنی وبسایت میپردازد تا موتورهای جستجو بتوانند سایت شما را به راحتی خزش (Crawl) و ایندکس (Index) کنند. این شامل موارد زیر است:
- نقشه سایت XML (XML Sitemap): فایلی که به موتورهای جستجو کمک میکند تا تمامی صفحات مهم وبسایت شما را پیدا کنند.
- فایل Robots.txt: به موتورهای جستجو میگوید که کدام بخشها را خزش نکنند.
- ساختار داده (Schema Markup): استفاده از کدهای نشانهگذاری برای کمک به موتورهای جستجو در درک بهتر محتوای شما، به خصوص برای اطلاعات تماس، خدمات پزشکی، ساعات کاری و نوبتدهی آنلاین.
- امنیت وبسایت (HTTPS): استفاده از گواهی SSL برای رمزگذاری ارتباطات.
تحقیق کلمات کلیدی تخصصی برای آزمایشگاههای پاتوبیولوژی
پایه و اساس هر استراتژی سئو آزمایشگاه پاتوبیولوژی موفق، تحقیق دقیق کلمات کلیدی است. شما باید بدانید که مراجعین بالقوه شما چه عبارتهایی را در گوگل جستجو میکنند تا به خدمات شما دسترسی پیدا کنند. این کلمات کلیدی باید هم عمومی باشند و هم بسیار تخصصی.
کلمات کلیدی محلی (Local Keywords)
برای آزمایشگاهی در مشهد، کلمات کلیدی محلی اهمیت فوقالعادهای دارند. مثالها:
- “آزمایشگاه پاتوبیولوژی در مشهد”
- “بهترین آزمایشگاه مشهد برای سونوگرافی”
- “آزمایش خون در منطقه احمدآباد مشهد”
- “نوبتدهی آنلاین آزمایش مشهد”
- “آزمایشگاه کرونا مشهد”
استفاده از نام محلهها و مناطق معروف مشهد (مانند هاشمیه، سجاد، وکیلآباد) در کنار کلمات کلیدی خدمات، میتواند ترافیک هدفمند محلی را به وبسایت شما هدایت کند.
کلمات کلیدی مرتبط با خدمات و آزمایشات
محتوای وبسایت شما باید غنی از کلمات کلیدی مربوط به آزمایشات و خدمات تخصصی باشد:
- “آزمایشات ژنتیک”
- “غربالگری سرطان”
- “تستهای هورمونی”
- “آنالیز ادرار”
- “آزمایشات بارداری”
- “پاتولوژی بافت”
علاوه بر این، سوالاتی که بیماران در مورد آزمایشها میپرسند (مثلاً “شرایط ناشتایی برای آزمایش قند خون چیست؟”) نیز میتوانند کلمات کلیدی طولانی (Long-Tail Keywords) مهمی باشند که باید در محتوای وبسایت شما گنجانده شوند.
بهینهسازی سیستم نوبتدهی آنلاین آزمایشگاه: کلید جذب مراجعین بیشتر
بهینه سازی نوبت دهی آنلاین آزمایشگاه تنها به معنای داشتن یک فرم در وبسایت نیست؛ بلکه بهینهسازی این سیستم برای سهولت استفاده، سرعت و اطمینان از دیده شدن آن در نتایج جستجو است. یک سیستم نوبتدهی آنلاین کارآمد میتواند به طور قابل توجهی افزایش مراجعین آزمایشگاه را به همراه داشته باشد و نیاز به تماسهای تلفنی متعدد را کاهش دهد.
تجربه کاربری (UX) در نوبتدهی آنلاین
رابط کاربری و تجربه کاربری (UI/UX) در سیستم نوبتدهی آنلاین شما باید در اولویت باشد. مراحل باید ساده، روشن و حداقل باشند. نکات کلیدی:
- فرمهای ساده: فقط اطلاعات ضروری را درخواست کنید.
- راهنمای گام به گام: دستورالعملهای واضح برای هر مرحله.
- پشتیبانی از موبایل: اطمینان از اینکه سیستم در گوشیهای هوشمند به راحتی قابل استفاده است.
- تأییدیه نوبت: ارسال تأییدیه از طریق ایمیل یا پیامک و امکان اضافه کردن به تقویم.
سئو فنی سیستم نوبتدهی
حتی سیستم نوبتدهی شما نیز باید برای سئو بهینه شود:
- سرعت بارگذاری: اطمینان از بارگذاری سریع صفحات نوبتدهی.
- کلمات کلیدی: استفاده از کلماتی مانند “نوبتدهی آزمایش آنلاین”، “رزرو آزمایشگاه” در عناوین و متن صفحات مربوطه.
- دسترسیپذیری: اطمینان از اینکه رباتهای گوگل میتوانند به صفحات نوبتدهی دسترسی داشته باشند (مگر اینکه عمداً آنها را از ایندکس شدن منع کنید).
- استفاده از دادههای ساختاریافته (Schema Markup): برای رویدادها یا خدمات، تا گوگل بتواند اطلاعات نوبتدهی شما را به شکل غنیتر (Rich Snippets) نمایش دهد.
اعتماد و امنیت در نوبتدهی اینترنتی
بیماران باید به امن بودن اطلاعات شخصی و پزشکی خود اعتماد داشته باشند:
- گواهی SSL: استفاده از HTTPS برای تمامی صفحات نوبتدهی.
- سیاست حفظ حریم خصوصی: داشتن یک صفحه واضح در مورد نحوه جمعآوری و استفاده از اطلاعات.
- پشتیبانی قوی: ارائه راههای ارتباطی واضح برای مشکلات احتمالی در فرآیند نوبتدهی.
نقش CRM پزشکی در مدیریت ارتباط با بیمار و سئو
CRM پزشکی (Customer Relationship Management) فراتر از یک ابزار ساده برای مدیریت دادههای بیماران است؛ این یک استراتژی جامع برای بهبود تجربه بیمار، افزایش وفاداری و در نهایت، تقویت بازاریابی دیجیتال آزمایشگاه شماست. یکپارچهسازی CRM پزشکی آزمایشگاه با وبسایت و سیستمهای دیگر، میتواند دادههای ارزشمندی را برای تصمیمگیریهای سئو و بازاریابی فراهم کند.
یکپارچهسازی CRM با وبسایت
وقتی یک سیستم CRM با وبسایت و سیستم نوبتدهی آنلاین شما یکپارچه میشود، مزایای بسیاری حاصل میشود:
- جمعآوری خودکار اطلاعات: اطلاعات بیماران از فرمهای نوبتدهی، تماسها و سایر تعاملات مستقیماً در CRM ذخیره میشوند.
- تاریخچه جامع بیمار: دسترسی به سوابق آزمایشات، نوبتها و ارتباطات پیشین بیمار.
- ارتباطات شخصیسازی شده: ارسال یادآوریهای نوبت، نتایج آزمایش و حتی پیشنهادهای بهداشتی مرتبط. این امر افزایش مراجعین آزمایشگاه را در پی دارد.
- بازخورد بیماران: ثبت و پیگیری نظرات و شکایات بیماران برای بهبود خدمات.
تاثیر CRM بر بازاریابی دیجیتال و وفاداری بیمار
- بهبود تجربه بیمار: با ارائه خدمات شخصیسازی شده، بیماران احساس ارزشمندی میکنند و احتمال بازگشت آنها بیشتر میشود.
- بازاریابی هدفمند: بر اساس دادههای CRM، میتوانید کمپینهای بازاریابی ایمیلی یا پیامکی هدفمند برای گروههای خاصی از بیماران (مثلاً یادآوری غربالگری سالانه) اجرا کنید.
- افزایش نظرات مثبت: بیماران راضی بیشتر تمایل دارند نظرات مثبت آنلاین بنویسند که برای سئو محلی بسیار مهم است.
- تحلیل دادهها: دادههای CRM میتوانند الگوهای رفتار بیماران را نشان دهند و به شما کمک کنند تا کلمات کلیدی جدیدی را کشف کرده و استراتژی بازاریابی دیجیتال آزمایشگاه خود را بهبود ببخشید.
آیا وبسایت آزمایشگاه شما نیاز به بازسازی یا بهینهسازی دارد؟
تیم حرفهای پینو سایت نه تنها در طراحی وبسایت در ایران پیشرو است، بلکه در ساخت سایت با آخرین فناوریهای روز مانند لاراول، ریاکت، ویو و نود جیاس تخصص دارد. ما به شما کمک میکنیم تا یک وبسایت فروشگاهی (برای خدمات شما) یا اطلاعاتی با بهترین قیمت طراحی وبسایت داشته باشید که به طور کامل برای سئو آزمایشگاه پاتوبیولوژی بهینه شده باشد.
با ما تماس بگیرید و مشاوره رایگان دریافت کنید
تلفن: ۰۹۹۲۷۰۲۸۴۶۳
استراتژیهای سئو محلی (Local SEO) برای آزمایشگاههای مشهد
سئو محلی برای آزمایشگاههای پاتوبیولوژی در شهری مانند مشهد که مراجعین عمدتاً از مناطق نزدیک به دنبال خدمات هستند، حیاتی است. هدف، نمایش داده شدن در “پک محلی” گوگل (Local Pack) و نقشه گوگل برای جستجوهای محلی است.
بهینهسازی پروفایل Google My Business
Google My Business (GMB) قدرتمندترین ابزار برای سئو محلی است:
- تکمیل اطلاعات: اطمینان از اینکه تمامی اطلاعات (نام، آدرس، شماره تلفن، ساعات کاری، وبسایت) دقیق و بهروز هستند.
- عکسهای با کیفیت: آپلود عکسهای با کیفیت از آزمایشگاه، تجهیزات و پرسنل.
- انتخاب دستهبندی مناسب: انتخاب دستهبندیهای دقیق و مرتبط (مثلاً “آزمایشگاه پزشکی”، “آزمایشگاه پاتولوژی”).
- پستها و بهروزرسانیها: استفاده از قابلیت پستهای GMB برای اطلاعرسانی در مورد اخبار، خدمات جدید یا تغییرات.
دریافت نظرات و امتیازات مثبت
نظرات مثبت بیماران در Google My Business و سایر پلتفرمها به شدت بر رتبه سئو محلی شما تأثیر میگذارد. به صورت فعال از بیماران راضی خود بخواهید تا نظر بدهند و به تمامی نظرات، چه مثبت و چه منفی، پاسخ حرفهای و مودبانه دهید. پاسخدهی نشان دهنده اهمیت شما به بیماران است و برای سئو آزمایشگاه پاتوبیولوژی بسیار مهم است.
ثبت در دایرکتوریهای محلی
اطمینان حاصل کنید که آزمایشگاه شما در دایرکتوریهای محلی و پزشکی آنلاین (مانند کتاب اول، ۱۱۸، مراکز درمانی مشهد) ثبت شده و اطلاعات آن یکپارچه و دقیق است. این به گوگل کمک میکند تا اعتبار و صحت اطلاعات کسبوکار شما را تأیید کند.
تولید محتوای ارزشمند و تخصصی برای آزمایشگاه
محتوا پادشاه است؛ این جمله در دنیای سئو همچنان صادق است. برای یک آزمایشگاه پاتوبیولوژی، تولید محتوای تخصصی و آموزشی نه تنها به سئو آزمایشگاه پاتوبیولوژی کمک میکند بلکه باعث افزایش اعتماد بیماران و جایگاه شما به عنوان یک مرجع معتبر میشود.
وبلاگ آزمایشگاه
یک وبلاگ فعال میتواند به شما در هدف قرار دادن کلمات کلیدی طولانی و پاسخ به سوالات رایج بیماران کمک کند. موضوعات میتوانند شامل موارد زیر باشند:
- “اهمیت آزمایشات غربالگری سالانه”
- “تفاوت آزمایش خون کامل و آزمایش CBC”
- “چه بیماریهایی با آزمایش ادرار تشخیص داده میشوند؟”
- “آمادگیهای لازم برای آزمایش قند خون”
این مقالات باید دقیق، از نظر علمی صحیح و به زبان ساده برای عموم مردم نوشته شوند.
صفحات خدمات جامع
برای هر خدمت یا آزمایش اصلی که ارائه میدهید، یک صفحه اختصاصی و جامع ایجاد کنید. این صفحات باید شامل:
- توضیحات کامل آزمایش
- نحوه انجام
- آمادگیهای لازم
- مدت زمان انتظار برای نتایج
- اهمیت و کاربرد آزمایش
این صفحات فرصتهای عالی برای استفاده از کلمات کلیدی تخصصی و بهبود سئو آزمایشگاه پاتوبیولوژی هستند.
پرسش و پاسخ (FAQ) تخصصی
یک بخش FAQ جامع که به سوالات پرتکرار بیماران در مورد آزمایشها، نحوه نوبتدهی، دریافت نتایج و موارد دیگر پاسخ میدهد، میتواند بسیار مفید باشد. این بخش نه تنها تجربه کاربری را بهبود میبخشد، بلکه میتواند به عنوان منبعی برای Rich Snippets در نتایج جستجو عمل کند و افزایش مراجعین آزمایشگاه را در پی داشته باشد.
بکلینکسازی و افزایش اعتبار دامنه (Domain Authority)
بکلینکها (لینکهایی که از وبسایتهای دیگر به وبسایت شما اشاره میکنند) یکی از مهمترین فاکتورهای رتبهبندی گوگل هستند. گوگل بکلینکها را به عنوان رأی اعتماد به محتوای شما تلقی میکند.
- همکاری با پزشکان و مراکز درمانی: درخواست تبادل لینک با وبسایت پزشکان متخصص، کلینیکها و بیمارستانهای معتبر در مشهد.
- انتشار محتوای قابل استناد: ایجاد محتوایی که سایر وبسایتها و مراجع بتوانند به آن لینک دهند (مثلاً یک مقاله تحقیقاتی، یک راهنمای جامع).
- حضور در رسانهها: اگر آزمایشگاه شما در خبرها یا مقالات محلی مطرح میشود، مطمئن شوید که لینک وبسایت شما نیز درج شده است.
- پشتیبانی وبسایتهای درمانی: شرکتهایی مانند پینو سایت میتوانند در استراتژیهای لینکسازی کلاه سفید به شما کمک کنند.
بازاریابی دیجیتال فراتر از سئو برای آزمایشگاهها
سئو یک ستون فقرات مهم است، اما بازاریابی دیجیتال آزمایشگاه شامل ابزارهای دیگری نیز میشود که میتوانند به صورت مکمل عمل کنند و افزایش مراجعین آزمایشگاه را به حداکثر برسانند.
رسانههای اجتماعی
حضور فعال در شبکههای اجتماعی مانند اینستاگرام، لینکدین و تلگرام میتواند به افزایش آگاهی از برند، تعامل با مخاطبان و هدایت ترافیک به وبسایت شما کمک کند. انتشار محتوای آموزشی، اخبار آزمایشگاه و پاسخ به سوالات کاربران در این پلتفرمها بسیار مؤثر است.
تبلیغات کلیکی (PPC)
کمپینهای Google Ads میتوانند به شما کمک کنند تا بلافاصله برای کلمات کلیدی رقابتی در صدر نتایج جستجو قرار بگیرید. این یک راه عالی برای جذب فوری ترافیک و مراجعین در حالی است که استراتژی سئو شما در حال نتیجه دادن است. استفاده از بازاریابی دیجیتال آزمایشگاه به صورت هدفمند و با بودجه مشخص میتواند بسیار مفید باشد.
ایمیل مارکتینگ
با جمعآوری ایمیلهای بیماران (با رضایت آنها)، میتوانید خبرنامههای منظم، یادآوریهای نوبت، نتایج آزمایش و اطلاعات بهداشتی مرتبط ارسال کنید. این کار به حفظ ارتباط و افزایش وفاداری بیماران کمک میکند.
نکات حرفهای برای نگهداری و بهبود مستمر سئو
نکته حرفهای: دنیای سئو همواره در حال تغییر است. الگوریتمهای گوگل به طور مداوم بهروز میشوند و استراتژیهای دیروز ممکن است امروز کارایی لازم را نداشته باشند. سرمایهگذاری در یک تیم یا مشاور سئو متخصص که با آخرین تغییرات آشناست و میتواند وبسایت شما را به طور مستمر رصد و بهینهسازی کند، حیاتی است. تحلیل دادههای گوگل آنالیتیکس و گوگل سرچ کنسول به صورت ماهانه برای شناسایی نقاط قوت و ضعف، ضروری است.
برای حفظ و بهبود مستمر رتبه سئو، نیاز به یک رویکرد جامع و پایدار دارید:
- پایش مداوم: استفاده از ابزارهایی مانند Google Analytics و Google Search Console برای رصد عملکرد وبسایت، ترافیک، کلمات کلیدی و خطاهای احتمالی.
- بهروزرسانی محتوا: محتوای قدیمی را به طور منظم بهروزرسانی کنید تا اطلاعات آن دقیق و مرتبط باقی بماند.
- بررسی رقبا: استراتژیهای سئو رقبای خود را زیر نظر بگیرید و از آنها الهام بگیرید یا نقاط ضعف آنها را شناسایی و از آن بهره ببرید.
- سرمایهگذاری در طراحی وبسایت: یک وبسایت قدیمی و کند به تلاشهای سئو شما آسیب میزند. بهینهسازی فنی مداوم و حتی بازطراحی دورهای وبسایت توسط یک تیم متخصص مانند پینو سایت، ضروری است.
آیا میخواهید رتبه وبسایت آزمایشگاه خود را در گوگل بهبود بخشید؟
تیم متخصص پینو سایت با تجربه فراوان در سئو آزمایشگاه پاتوبیولوژی و بازاریابی دیجیتال آزمایشگاه، آماده است تا با استراتژیهای نوین و استفاده از تکنولوژیهایی مانند لاراول، ریاکت، ویو و نود جیاس، وبسایت شما را به یک ابزار قدرتمند برای افزایش مراجعین آزمایشگاه تبدیل کند. ما در زمینه طراحی وبسایت در ایران و ارائه راهکارهای جامع قیمت طراحی وبسایت رقابتی پیشتاز هستیم.
برای مشاوره رایگان با ما تماس بگیرید
تلفن: ۰۹۹۲۷۰۲۸۴۶۳
سوالات متداول (FAQ)
در این بخش به برخی از سوالات رایج پیرامون سئو آزمایشگاه پاتوبیولوژی و حضور دیجیتال پاسخ میدهیم:
سؤال ۱: چرا سئو برای آزمایشگاه پاتوبیولوژی در مشهد حیاتی است؟
پاسخ: در شهری با رقابت بالا مانند مشهد، بیماران به طور فزایندهای به دنبال خدمات پزشکی در اینترنت هستند. سئو به آزمایشگاه شما کمک میکند تا در نتایج جستجو دیده شوید، اعتبار کسب کنید و افزایش مراجعین آزمایشگاه را تجربه کنید.
سؤال ۲: چگونه میتوانیم سیستم نوبتدهی آنلاین آزمایشگاه خود را برای سئو بهینه کنیم؟
پاسخ: با اطمینان از سرعت بارگذاری بالا، طراحی واکنشگرا برای موبایل، استفاده از کلمات کلیدی مرتبط در عناوین و توضیحات، و پیادهسازی دادههای ساختاریافته (Schema Markup) میتوان این سیستم را بهینهسازی کرد.
سؤال ۳: نقش CRM پزشکی آزمایشگاه در استراتژی سئو چیست؟
پاسخ: یکپارچهسازی CRM با وبسایت به شما امکان میدهد تا تجربه بیمار را بهبود بخشید، ارتباطات شخصیسازی شده برقرار کنید و از دادههای جمعآوری شده برای بازاریابی هدفمند و افزایش نظرات مثبت آنلاین که مستقیماً بر سئو محلی تأثیر میگذارد، استفاده کنید.
سؤال ۴: چگونه میتوانیم برای آزمایشگاه پاتوبیولوژی خود در مشهد بکلینکهای با کیفیت بگیریم؟
پاسخ: با همکاری با پزشکان، کلینیکها و بیمارستانهای محلی، انتشار محتوای تخصصی و قابل استناد، و فعال بودن در رسانههای محلی میتوانید بکلینکهای معتبری کسب کنید.
سؤال ۵: آیا طراحی وبسایت توسط پینو سایت شامل خدمات سئو نیز میشود؟
پاسخ: بله، پینو سایت در طراحی وبسایت در ایران و ساخت سایت، اصول سئو را از ابتدا در نظر میگیرد. علاوه بر این، خدمات تخصصی سئو و بازاریابی دیجیتال آزمایشگاه نیز به صورت مجزا ارائه میشود تا وبسایت شما به بالاترین رتبهها دست یابد.
سؤال ۶: چه مدت طول میکشد تا نتایج سئو برای آزمایشگاه پاتوبیولوژی ما در مشهد مشاهده شود؟
پاسخ: سئو یک فرآیند زمانبر است و نتایج معمولاً پس از ۳ تا ۶ ماه شروع به ظهور میکنند و در بلندمدت پایدارتر میشوند. این زمان به رقابت، وضعیت فعلی وبسایت و کیفیت اجرای استراتژیها بستگی دارد.
آیا سوال دیگری دارید؟ با مشاورین ما در پینو سایت تماس بگیرید: ۰۹۹۲۷۰۲۸۴۶۳
آیا آمادهاید تا آزمایشگاه خود را در دنیای دیجیتال متحول کنید؟
تیم پینو سایت، با تخصص در طراحی وبسایت و سئو آزمایشگاه پاتوبیولوژی، آماده است تا با راهکارهای سفارشی و مدرن (بر پایه لاراول، ریاکت، ویو و نود جیاس)، به شما در افزایش مراجعین آزمایشگاه و بهبود مدیریت ارتباط با بیماران کمک کند. برای کسب اطلاعات بیشتر در مورد قیمت طراحی وبسایت و خدمات تخصصی ما، همین الان با ما تماس بگیرید.
تلفن: ۰۹۹۲۷۰۲۸۴۶۳
نتیجهگیری و گامهای بعدی
در سال ۲۰۲۶ و فراتر از آن، موفقیت یک آزمایشگاه پاتوبیولوژی در مشهد به شدت به قدرت حضور دیجیتال آن بستگی دارد. سئو آزمایشگاه پاتوبیولوژی دیگر یک گزینه نیست، بلکه یک سرمایهگذاری ضروری برای بقا و رشد است. با تمرکز بر بهینه سازی نوبت دهی آنلاین آزمایشگاه، یکپارچهسازی CRM پزشکی، استراتژیهای سئو محلی و تولید محتوای ارزشمند، میتوانید نه تنها رتبه وبسایت خود را در موتورهای جستجو بهبود بخشید، بلکه تجربه بینظیری برای مراجعین خود خلق کرده و به طور چشمگیری افزایش مراجعین آزمایشگاه را محقق سازید.
به یاد داشته باشید که سئو یک فرآیند مداوم است و نیازمند پایش، تحلیل و بهروزرسانی مستمر است. همکاری با متخصصین بازاریابی دیجیتال آزمایشگاه که در طراحی وبسایت در ایران و ساخت سایتهای تخصصی پزشکی دانش و تجربه دارند، میتواند شما را در این مسیر پیچیده یاری رساند. هماکنون زمان آن رسیده است که با یک استراتژی دیجیتال جامع، آزمایشگاه خود را برای آینده آماده کنید.
گام اول برای دیده شدن، طراحی وبسایتی حرفهای است.